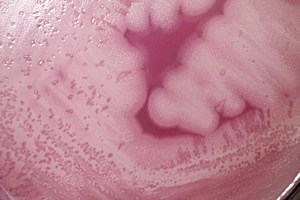
bacillus

La bacteria Bacillus thuringiensis es utilizada con éxito como alternativa biológica al uso de pesticidas químicos para el control de insectos. No obstante, su gran parecido con Bacillus cereus, capaz de producir intoxicaciones alimentarias en humanos, hace dificil distinguirla en los diagnósticos y evaluar correctamente su riesgo potencial de producir enfermedades gastrointestinales en los consumidores.
¿Puede Bacillus thuringiensis ser un riesgo para la seguridad alimentaria?
El grupo bacteriano Bacillus cereus sensu lato incluye ocho especies, entre ellas Bacillus cereus, una bacteria ubicua en el medio ambiente, que puede estar presente en una amplia gama de alimentos y causar enfermedades gastrointestinales en humanos, generalmente con vómitos y diarrea, y Bacillus thuringiensis, que se utiliza como insecticida biológico.
El grupo bacteriano Bacillus cereus sensu lato incluye ocho especies, entre ellas Bacillus cereus, una bacteria ubicua en el medio ambiente, que puede estar presente en una amplia gama de alimentos y causar enfermedades gastrointestinales en humanos, generalmente con vómitos y diarrea, y Bacillus thuringiensis, que se utiliza como insecticida biológico.
Dado que los métodos estandar para la detección y enumeración de microorganismos del grupo Bacillus cereus no distinguen fácilmente B. cereus de B. thuringiensis, el diagnóstico de las intoxicaciones por Bacillus es dificil, ya que pueden estar relacionadas con diversas especies, principalmente Bacillus cereus sensu stricto pero no únicamente, y no hay métodos que distingan las cepas patógenas entre estas especies.
La taxonomía actual del grupo B. cereus y el estatus de las especies separadas se basan principalmente en las características fenotípicas. Las cepas de Bacillus thuringiensis muestran un repertorio similar de los posibles genes de virulencia en el cromosoma como las cepas de B. cereus sensu stricto y se ha demostrado que estos genes también pueden expresarse activamente en las cepas de B. thuringiensis.
Las cepas de Bacillus cereus y B. thuringiensis por lo general no son discriminadas en los diagnósticos clínicos o en la microbiología de los alimentos. Por lo tanto, actualmente se desconoce la contribución real de las dos especies a casos de enfermedades gastrointestinales y no gastrointestinales.
Entre 2007 y 2014, los Estados Miembros notificaron 413 brotes alimentarios con una fuerte evidencia de estar relacionados con Bacillus cereus, que afectaron a 6.657 personas y causaron 352 hospitalizaciones.
Recientemente, expertos de la Agencia Europea para la Seguridad Alimentaria (EFSA) han actualizado un dictamen científico sobre los riesgos para la salud pública relacionados con Bacillus cereus y otras especies de Bacillus en los alimentos.
La conclusión de la EFSA es que la única manera de identificar las cepas del grupo Bacillus cereus sensu lato de manera no ambigua es determinar la secuencia completa de su genoma, y recomienda las técnicas de secuenciación completa del genoma para recoger información como un pre-requisito para una posterior evaluación de riesgo.
El grupo de expertos ha recomendado la aplicación de esta técnica para conseguir una identificación inequívoca de las cepas utilizadas como bioplaguicidas, asi como la caracterización detallada de las cepas responsables de los brotes, permitiendo la diferenciación entre B. thuringiensis y B. cereus.
La EFSA también señala como necesario realizar estudios de campo después de la aplicación de biopesticidas a base de B. thuringiensis que permitan fijar intervalos previos a la cosecha.
Fuente: Risks for public health related to the presence of Bacillus cereus and otherBacillus spp. including Bacillus thuringiensis in foodstuffs, EFSA Journal, julio 2016
Imagen: Bacillus thuringiensis, CDC (Dr. Todd Parker. Ph.D.; Assoc. Director for Lab. Science/DPEI(Acting) and LRN Training Coordinator)

